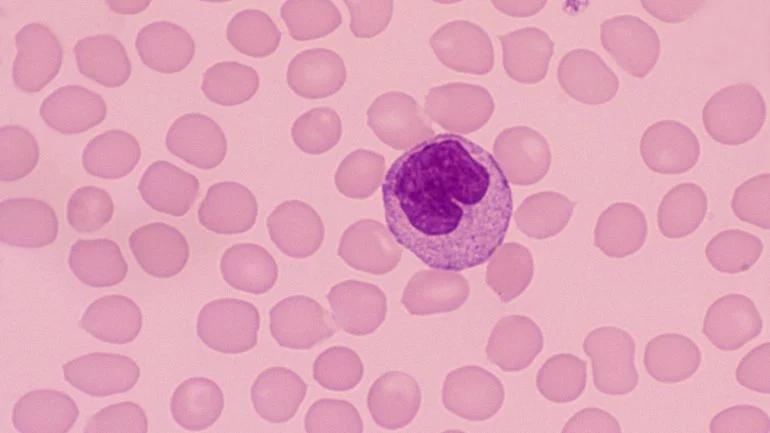

Die Anzahl der Monozyten im Blut ist ein wichtiger Indikator für die Gesundheit des Körpers. Monozyten sind eine Art von weißen Blutkörperchen, die eine wichtige Rolle bei der Bekämpfung von Infektionen und Entzündungen spielen. Sie sind die größten der weißen Blutkörperchen und machen etwa 4 bis 13 Prozent der Gesamtzahl der weißen Blutkörperchen aus.

Was sind Monozyten?
Monozyten sind eine Art von weißen Blutkörperchen, die im Knochenmark gebildet werden. Sie gehören zu den sogenannten Phagozyten, das heißt, sie können Krankheitserreger, wie Bakterien, Viren und Pilze, aufnehmen und zerstören.
Monozyten zirkulieren im Blut und wandern dann in verschiedene Gewebe, wo sie sich zu Makrophagen entwickeln. Makrophagen sind größere Zellen, die eine noch stärkere Phagozytose-Aktivität haben. Sie sind auch an der Immunantwort beteiligt und helfen, das Immunsystem zu regulieren.
Wie hoch darf der Monozyten-Wert sein?
Der normale Monozyten-Wert im Blut liegt zwischen 200 und 800 Monozyten pro Mikroliter Blut. Dies entspricht einem Anteil von 4 bis 13 Prozent an der Gesamtzahl der weißen Blutkörperchen.
Ein erhöhter Monozyten-Wert ( Monozytose ) kann auf verschiedene Erkrankungen hindeuten, darunter:
- Infektionen, z. B. Bakterielle Endokarditis (Herzinnenhautentzündung), Malaria, Tuberkulose
- Entzündungen, z. B. Chronisch-entzündliche Darmerkrankungen, Rheumatoide Arthritis
- Krebs, z. B. Leukämie, Lymphknotenkrebs
- Autoimmunerkrankungen, z. B. Lupus erythematodes
- Andere Erkrankungen, z. B. Sarkoidose, Morbus Crohn
Ein erniedrigter Monozyten-Wert ( Monozytopenie ) ist seltener und kann auf verschiedene Erkrankungen hindeuten, darunter:
- Schwere Infektionen
- Chemotherapie
- Strahlentherapie
- Immunsuppression
- Knochenmarkserkrankungen
Was bedeutet ein erhöhter Monozyten-Wert?
Ein erhöhter Monozyten-Wert (Monozytose) kann auf verschiedene Erkrankungen hindeuten. Eine Monozytose kann ein Hinweis auf eine Infektion sein, da Monozyten zur Bekämpfung von Infektionen eingesetzt werden. Sie kann aber auch ein Zeichen für eine Entzündung oder eine Krebserkrankung sein.
Es ist wichtig, dass ein Arzt den erhöhten Monozyten-Wert im Kontext anderer Symptome und Laborwerte betrachtet, um die Ursache für die erhöhte Anzahl an Monozyten zu ermitteln.
Was bedeutet ein erniedrigter Monozyten-Wert?
Ein erniedrigter Monozyten-Wert (Monozytopenie) ist seltener und kann auf verschiedene Erkrankungen hindeuten. Eine Monozytopenie kann ein Hinweis auf eine schwere Infektion, eine Chemotherapie oder eine Strahlentherapie sein. Sie kann auch ein Zeichen für eine Immunsuppression oder eine Knochenmarkserkrankung sein.
Es ist wichtig, dass ein Arzt den erniedrigten Monozyten-Wert im Kontext anderer Symptome und Laborwerte betrachtet, um die Ursache für die verringerte Anzahl an Monozyten zu ermitteln.
Wie wird der Monozyten-Wert gemessen?
Der Monozyten-Wert wird im Rahmen eines großen Blutbildes gemessen. Ein großes Blutbild ist ein „kleines Blutbild“ plus „Differenzialblutbild“, wobei hier zusätzlich die verschiedenen Typen der weißen Blutkörperchen genau untersucht werden.
Bei einem großen Blutbild werden die einzelnen Typen der weißen Blutkörperchen unter dem Mikroskop gezählt und ausgewertet.
Wann sollte man einen Arzt aufsuchen?
Wenn Sie sich Sorgen um Ihren Monozyten-Wert machen, sollten Sie einen Arzt aufsuchen. Es ist wichtig, dass Sie alle Symptome, die Sie haben, mit Ihrem Arzt besprechen, damit er die Ursache für die Veränderung Ihres Monozyten-Wertes feststellen kann.
Häufig gestellte Fragen
Was ist ein normales Monozyten-Wert?
Der normale Monozyten-Wert im Blut liegt zwischen 200 und 800 Monozyten pro Mikroliter Blut. Dies entspricht einem Anteil von 4 bis 13 Prozent an der Gesamtzahl der weißen Blutkörperchen.
Was bedeutet ein erhöhter Monozyten-Wert?
Ein erhöhter Monozyten-Wert (Monozytose) kann auf verschiedene Erkrankungen hindeuten, darunter Infektionen, Entzündungen, Krebs und Autoimmunerkrankungen. Es ist wichtig, dass ein Arzt den erhöhten Monozyten-Wert im Kontext anderer Symptome und Laborwerte betrachtet, um die Ursache für die erhöhte Anzahl an Monozyten zu ermitteln.
Was bedeutet ein erniedrigter Monozyten-Wert?
Ein erniedrigter Monozyten-Wert (Monozytopenie) ist seltener und kann auf verschiedene Erkrankungen hindeuten, darunter schwere Infektionen, Chemotherapie, Strahlentherapie, Immunsuppression und Knochenmarkserkrankungen. Es ist wichtig, dass ein Arzt den erniedrigten Monozyten-Wert im Kontext anderer Symptome und Laborwerte betrachtet, um die Ursache für die verringerte Anzahl an Monozyten zu ermitteln.
Wie wird der Monozyten-Wert gemessen?
Der Monozyten-Wert wird im Rahmen eines großen Blutbildes gemessen. Bei einem großen Blutbild werden die einzelnen Typen der weißen Blutkörperchen unter dem Mikroskop gezählt und ausgewertet.
Wann sollte man einen Arzt aufsuchen?
Wenn Sie sich Sorgen um Ihren Monozyten-Wert machen, sollten Sie einen Arzt aufsuchen. Es ist wichtig, dass Sie alle Symptome, die Sie haben, mit Ihrem Arzt besprechen, damit er die Ursache für die Veränderung Ihres Monozyten-Wertes feststellen kann.
Zusammenfassung
Der Monozyten-Wert ist ein wichtiger Indikator für die Gesundheit des Körpers. Ein erhöhter oder erniedrigter Monozyten-Wert kann auf verschiedene Erkrankungen hindeuten. Es ist wichtig, dass ein Arzt den Monozyten-Wert im Kontext anderer Symptome und Laborwerte betrachtet, um die Ursache für die Veränderung des Monozyten-Wertes zu ermitteln.
Wenn Sie andere Artikel kennenlernen möchten, die Monozyten-wert normal: was ist der referenzbereich? ähneln, können Sie die Kategorie Blutwerte besuchen.